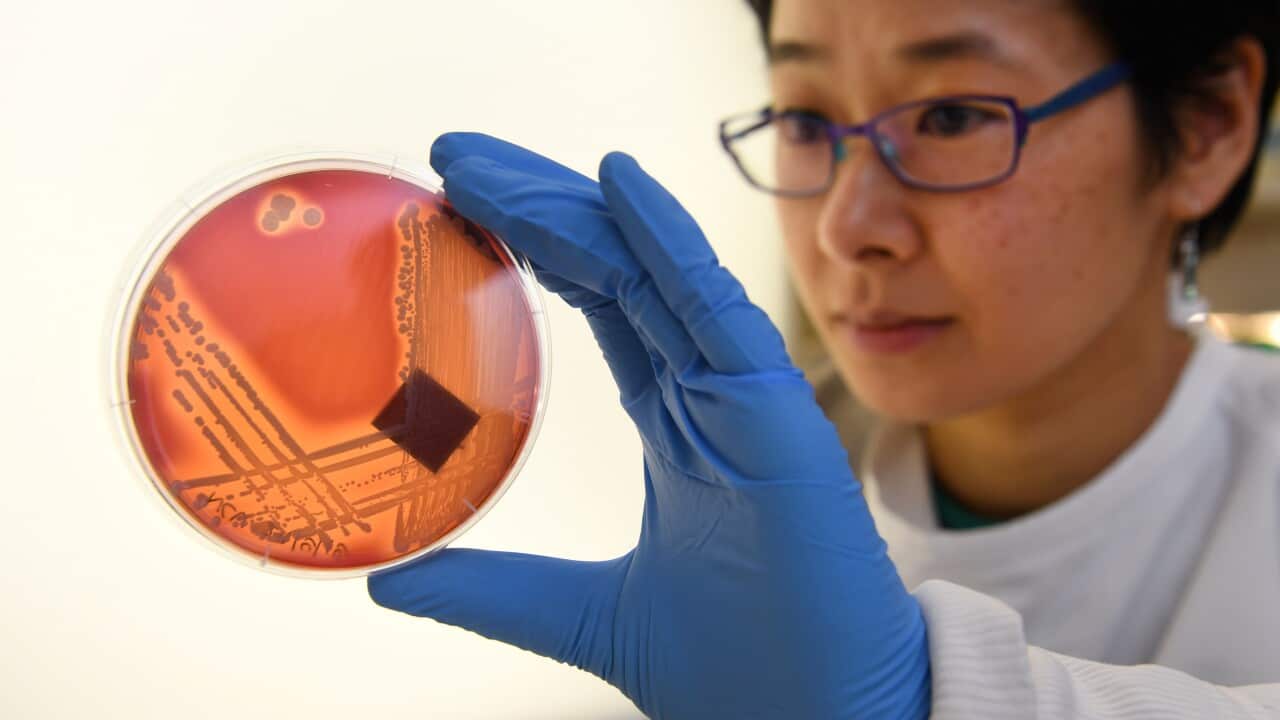

澳大利亚正面临百日咳爆发的情况。2024年前三个月共记录了约2799例病例。昆州和新州的病例最多,均记录了1000多例。
昆州上一次在三个月内记录超过1000例是在2013年第一季度。
再之前,2008年至2012年期间,澳大利亚爆发了严重的百日咳情况。这是自20世纪50年代广泛推广百日咳疫苗以来,澳大利亚记录的最大一次百日咳爆发。
这一期间记录了超过14万例病例,其中 2011 年病例数最高,达38748 例。
2014年至2017年期间曾出现过一次规模较小的爆发,这几年的病例数超过 6 万例。
READ MORE

澳洲专家详解:下一轮新冠疫情何时到来?今冬面临哪些挑战?
百日咳是什么?如何保护自己?
此病对婴儿来说最为危险。百日咳是一种严重且传染性极强的呼吸道疾病,由百日咳杆菌引起。
百日咳的最初症状类似于其他感冒和流感症状。 这些症状包括流鼻涕、打喷嚏、轻微咳嗽和发烧。但随着病情进入第二周,咳嗽变得更加严重和频繁。
咳嗽之后或咳嗽间歇期,患者可能会喘气并发出特有的“呼呼”声。
这种疾病被称为“百日咳”,因为它可以持续6至12周。
对于尚未接种疫苗的新生儿来说,这种疾病尤其严重,可能会危及生命。
对于完全接种了疫苗的大龄儿童以及青少年和成年人来说,这种疾病的严重程度通常较低。然而,即使在成年人中,咳嗽也可能导致肋骨骨折。

百日咳的最初症状类似于其他感冒和流感样症状。 Source: Getty / FatCamera
首先最好的保护措施是接种疫苗,这可以预防大多数严重疾病,并减少百日咳在社区中的传播。
建议婴幼儿和儿童在约2个月至13岁之间接种六剂百日咳疫苗(与其他疾病的疫苗一起接种)。
根据国家免疫计划,儿童和孕妇可以免费接种疫苗。妇女在怀孕期间接种百日咳疫苗,可以为新生儿在出生后头几个月提供保护。
这些疫苗的免疫力会随着时间的推移而减弱,因此建议成年人也接种加强针,特别是那些可能经常与婴儿接触的人。
READ MORE

大病小病都用抗生素?新报告:澳抗生素处方率上升 耐药性有何危害?
为何现在病例上升?
一般来说,百日咳每三至四年爆发一次。
在2020至23年期间,由于采取边境封锁、社交隔离和佩戴口罩等新冠疫情防范措施,澳大利亚百日咳的病例数量大幅下降。
如果按照通常的爆发周期,那么现在可能就是我们看到又一次百日咳爆发的时候。
在新冠疫情最严重时,错过了常规百日咳疫苗接种,可能意味着澳大利亚人现在更容易受到此病的感染。
澳大利亚以及英国和美国等其他国家百日咳病例增加,人群免疫力下降可能是原因之一。
在澳大利亚,此次百日咳爆发期间,10至14岁儿童的病例尤其多。
READ MORE
对无声大流行的担忧:超级细菌有多危险?澳洲可以采取什么措施?
潜在的超级细菌
在过去的20年里,百日咳越来越善于躲避疫苗和抗生素。
澳大利亚和其他发达国家使用的大多数疫苗都会刺激人体免疫系统识别,并针对三到五种细菌成分。。
随着时间的推移,引起百日咳的细菌在这些基因中逐渐发生突变。
这些突变使细菌看起来与疫苗中使用的细菌略有不同,从而令其更好地躲避免疫系统。
大多数基因突变都很小。但在2008年,澳大利亚出现了一种新菌株,它不再产生百日咳黏附素(pertactin),而百日咳黏附素是疫苗所针对的成分之一。
这意味着你的免疫系统就像侦探一样,少了一个线索来识别细菌。
在不到10年的时间里,这种新菌株从占比为5%迅速增加,成为占主导的菌株,到2017年已占90%。
研究显示,这种百日咳黏附素阴性菌株在接种了疫苗的小鼠体内存活率更高,这可能是导致2008至2012年爆发时病例数量增多的原因之一。
令人担忧的是,自2013年以来,抗生素耐药性百日咳菌株已在中国广泛传播。
虽然还有其他抗生素可用,但不建议用于两个月以下的婴儿(该年龄段患严重疾病的风险最高)。
这些耐药菌株正在亚洲各地蔓延,但尚未在澳大利亚出现。

随着百日咳发展到第二周,咳嗽变得更严重,更频繁。在咳嗽之后或咳嗽之间,病人可能会喘气并发出特有的“呼呼”声。 Source: Getty / BSIP/Universal Images Group
下一步怎么办?
目前还无法知道这次百日咳爆发的规模有多大,或者是由哪些菌株引起的。
我们需要对百日咳菌株进行更深入的追踪,就像对待新冠一样,以便为未来的疫苗设计和治疗提供参考。
重要的是,尽管这种细菌正在进化,但目前的疫苗在预防严重疾病和减少传播方面仍然非常有效。它们仍然是我们遏制百日咳爆发的最佳工具。
为了保护自己、脆弱的新生儿和更广泛的社区,每个人都应确保自己及时接种了最新的百日咳疫苗。
如果您有疑问,可以向您的全科医生(GP)咨询。
任何有感冒或流感样症状的人都应远离婴儿。
欢迎下载应用程序SBS Audio,关注Mandarin。您也可以通过苹果播客、Spotify等播客平台随时收听和下载SBS普通话音频故事。
分享



